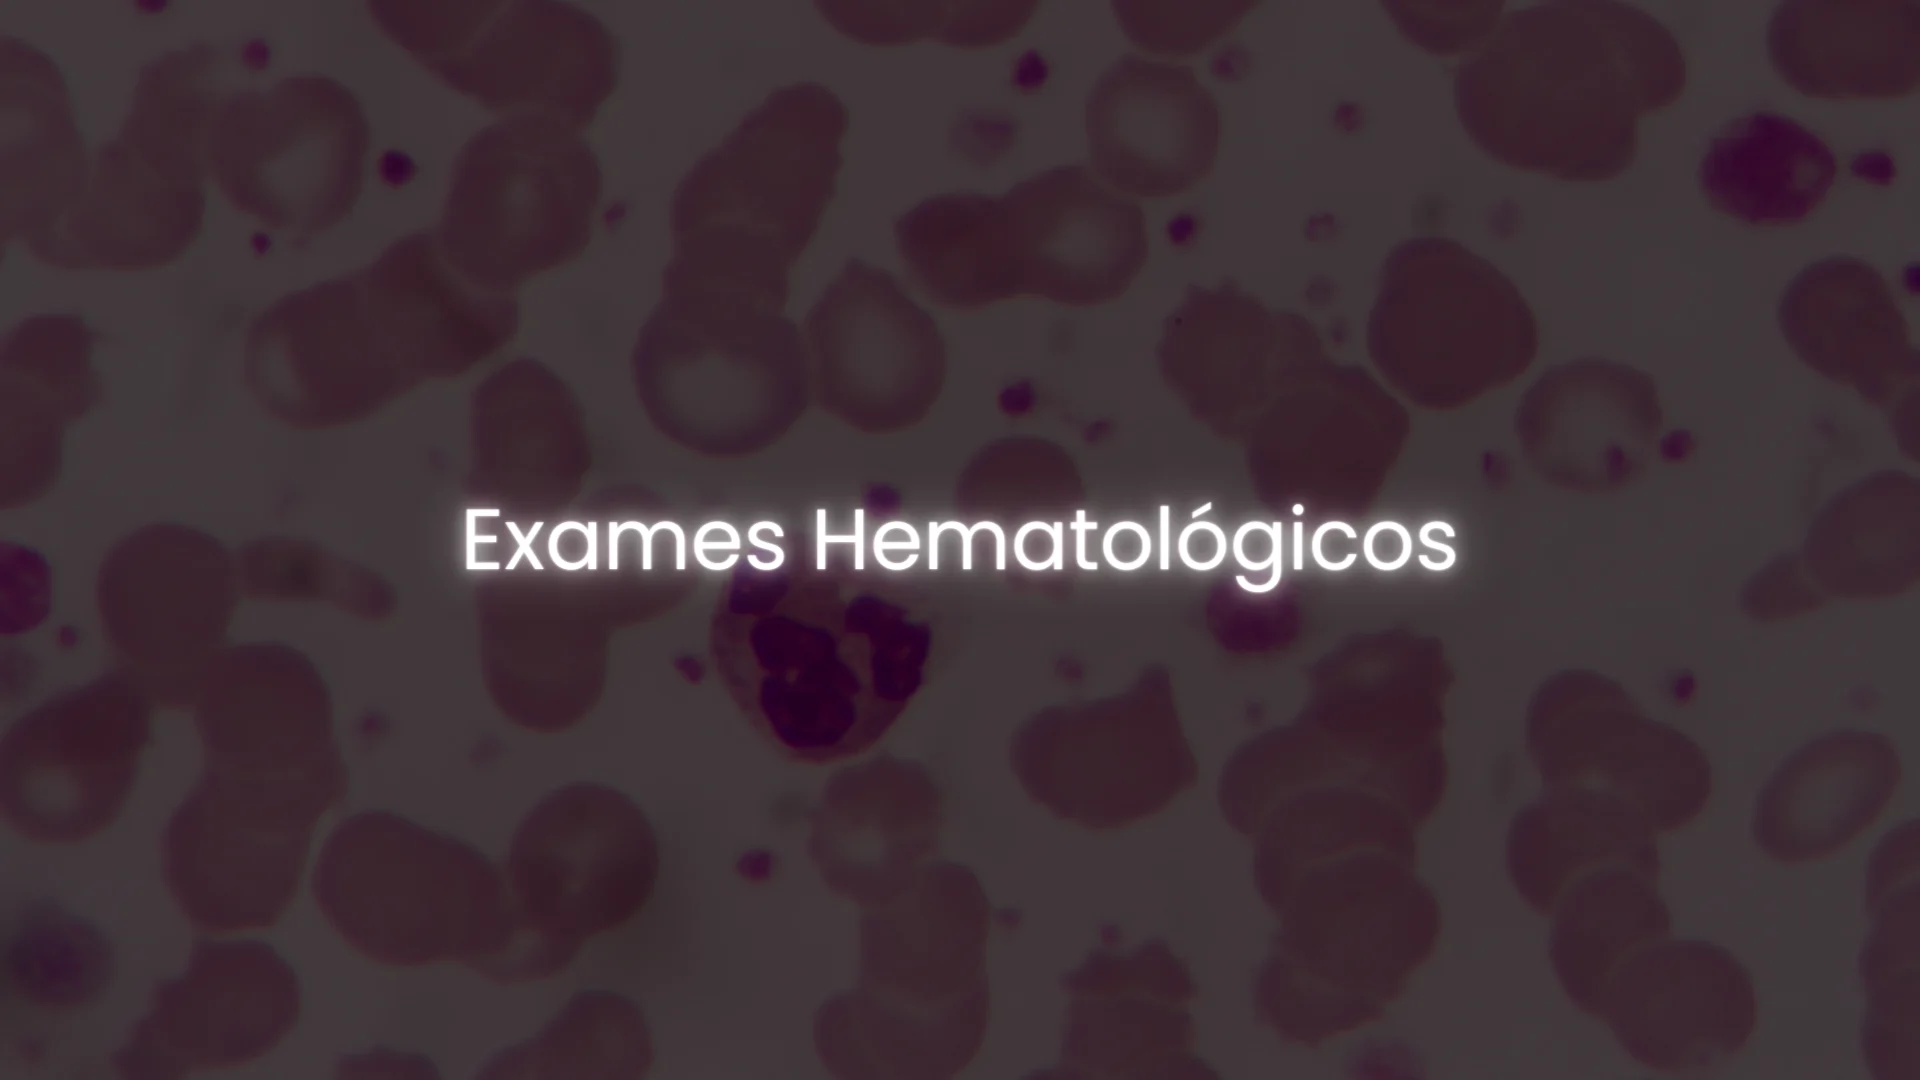
matérias - hemato on 1

Seu coordenador, joaca!
Sou Biólogo, especialista em Hematologia, Hemoterapia, Análises Clínicas e Estética.
Além disso, sou Mestre em Patologia Molecular e atuo como Analista do SES-DF.
Fui professor Universitário por mais de 15 anos e há 5 anos fundei o ISAX (Instituto de saúde Aplicada X) para fazer o que eu mais amo na vida: Ensinar!